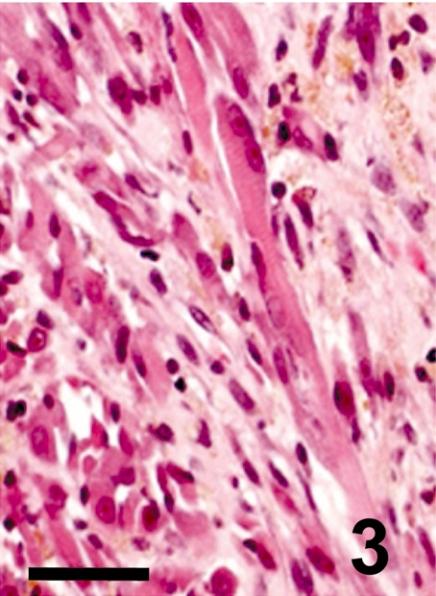

一只狗的喉部发生的横纹肌肉瘤。
A rhabdomyosarcoma arising in the larynx of a dog.
作者信息
Yamate Jyoji, Murai Fumi, Izawa Takeshi, Akiyoshi Hideo, Shimizu Junichiro, Ohashi Fumihito, Kuwamura Mitsuru
出版信息
J Toxicol Pathol. 2011 Sep;24(3):179-82. doi: 10.1293/tox.24.179. Epub 2011 Oct 12.
A neoplastic nodular lesion, 2 × 3 cm in diameter, was found in the larynx of a 6-year-old spayed female dog. The tumor was ill-circumscribed, consisting histologically of large round cells with abundant cytoplasm interspersed with small round cells with less cytoplasm and occasional multinucleated cells (myotubes). Immunohistochemically, tumor cells were positive for myoglobin, desmin and vimentin in varying degrees, but negative for S-100 protein, GFAP or cytokeratin. Cytoplasmic myofilaments/myofibrils with a dense Z-line-like structure were seen, the fine structures of which were complemented by PTAH stain. Based on these findings, the tumor was diagnosed as a rhabdomyosarcoma, a very rare tumor in the larynx of dogs.
在一只6岁已绝育的雌性犬的喉部发现了一个直径为2×3厘米的肿瘤性结节病变。该肿瘤边界不清,组织学上由具有丰富细胞质的大圆形细胞组成,其间散布着细胞质较少的小圆形细胞和偶尔的多核细胞(肌管)。免疫组织化学检查显示,肿瘤细胞肌红蛋白、结蛋白和波形蛋白呈不同程度阳性,但S-100蛋白、胶质纤维酸性蛋白或细胞角蛋白呈阴性。可见具有致密Z线样结构的细胞质肌丝/肌原纤维,其精细结构经磷钨酸苏木精染色得以补充。基于这些发现,该肿瘤被诊断为横纹肌肉瘤,这在犬类喉部是一种非常罕见的肿瘤。